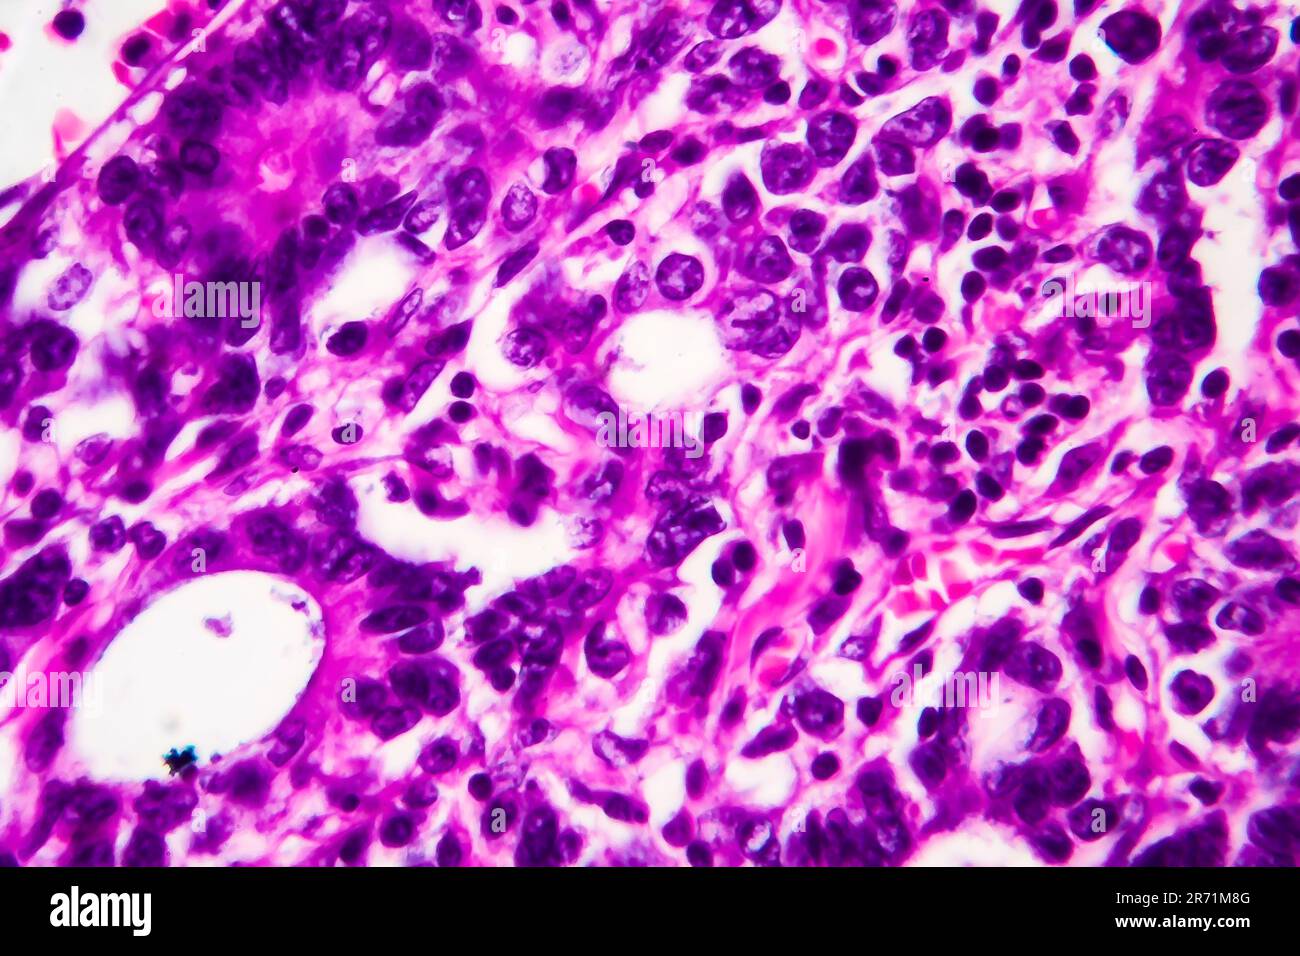
Adénocarcinome gastrique, micrographe léger, photo sous microscope. Agrandissement élevé Banque D'Images

Adénocarcinome gastrique, micrographe léger, photo sous microscope. Agrandissement élevé
RFID:ID de l’image:2R71M8G
Détails de l'image
Contributeur:
Dr_MicrobeID de l’image:
2R71M8GTaille du fichier:
33,4 MB (1,3 MB Téléchargement compressé)Autorisations:
Modèle - non | Propriété - nonUne autorisation est-elle nécessaire?Dimensions:
4186 x 2791 px | 35,4 x 23,6 cm | 14 x 9,3 inches | 300dpiDate de la prise de vue:
9 août 2019